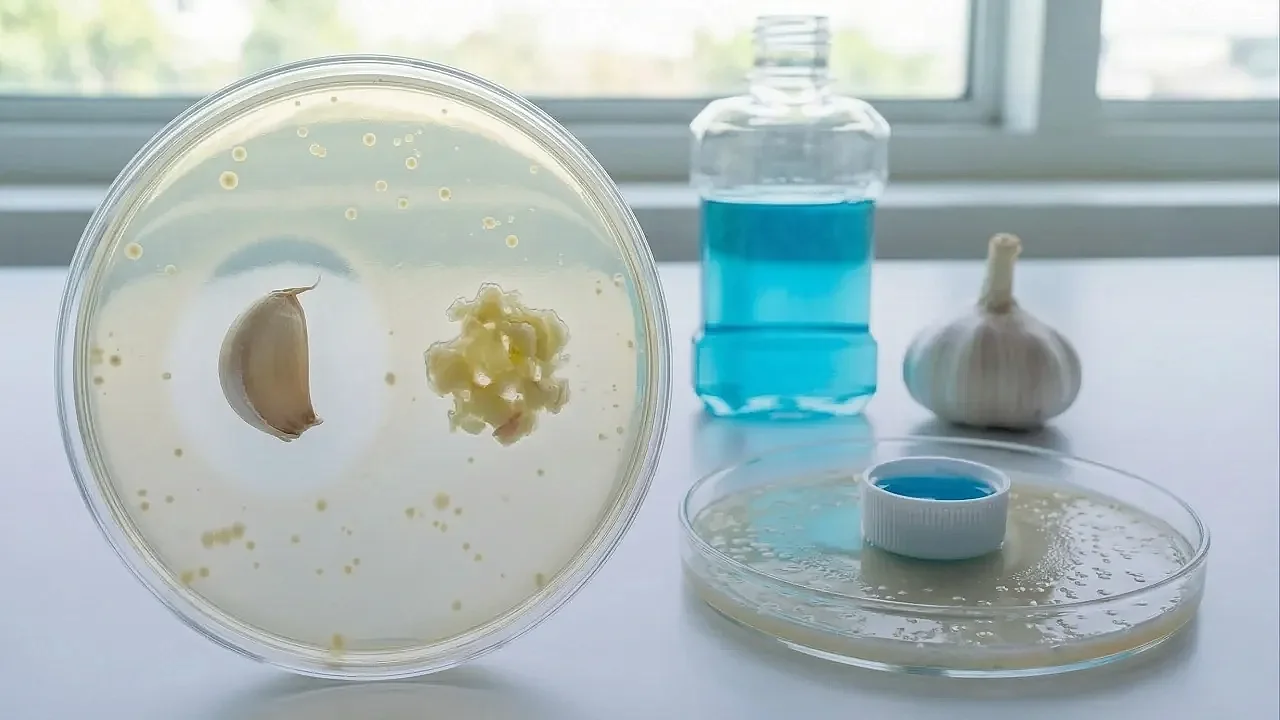

Reklam
Yeni bir bilimsel araştırma, sarımsağın ağız sağlığında uzun süredir “altın standart” kabul edilen kimyasal gargaralarla yarışabildiğini, hatta belirli koşullarda onları geride bıraktığını ortaya koydu. Bulgular, ağız bakımında doğal alternatiflerin yeniden gündeme gelmesine yol açtı.Birleşik Arap Emirlikleri’nde Sharjah Üniversitesi’nden bir araştırma ekibi tarafından yürütülen çalışmada, sarımsak özütünün ağız içi bakterilere karşı etkisi ayrıntılı biçimde incelendi. Sonuçlar, hakemli bilimsel dergi Journal of Herbal Medicine’de yayımlandı.
Kaynak: Haber Merkezi / Journal of Herbal Medicine
Yüzde 3 eşik noktası oldu
Araştırmaya göre sarımsak özütü içeren gargaralar, diş çürümelerinin başlıca nedeni olarak bilinen Mutans Streptococci bakterisini yok etmede dikkat çekici sonuçlar verdi. Özellikle yüzde 3’lük konsantrasyona ulaşıldığında, sarımsak bazlı solüsyonların klorheksidin içeren güçlü kimyasal gargaralardan daha etkili olduğu belirlendi.Araştırmacılar, sarımsağın etkisinin yoğunluğa doğrudan bağlı olduğunu vurguladı. Yüzde 2,5 seviyesindeki çözeltilerin standart gargaraların gerisinde kaldığı, ancak yüzde 3 eşiğinin aşılmasıyla sonuçların belirgin biçimde değiştiği aktarıldı.Kimyasal gargaralara neden alternatif aranıyor?
Bilim insanlarını bu çalışmaya yönelten temel nedenlerden biri, yaygın olarak kullanılan klorheksidin bazlı gargaraların yan etkileri oldu. Uzun süreli kullanımda dişlerde kalıcı lekelenme oluşabildiği, daha önemlisi ise bakterilerin zamanla bu kimyasallara karşı direnç geliştirebildiği belirtiliyor.Uzmanlara göre bu durum, yalnızca ağız sağlığıyla sınırlı kalmayıp, genel antibiyotik direncini de tetikleyebilecek ciddi bir halk sağlığı sorununa dönüşme potansiyeli taşıyor.Sarımsağın gücü nereden geliyor?
Sarımsağın binlerce yıldır Roma, Mısır ve Çin gibi kadim uygarlıklarda tıbbi amaçlarla kullanılmasının temelinde, “allicin” adı verilen aktif bileşik yer alıyor. Sarımsak ezildiğinde ya da doğrandığında açığa çıkan bu madde, bakterilerin çoğalmasını engelliyor ve hücre stresini azaltıyor.Araştırmacılar, allicin sayesinde sarımsağın ağız içindeki zararlı bakteriler üzerinde güçlü bir baskı oluşturduğunu değerlendiriyor.Yan etkiler de var
Buna karşın sarımsak bazlı gargaraların bazı olumsuz yönleri de bulunuyor. Çalışmaya katılan gönüllüler, keskin tat, ağız kokusu ve ağız içinde baharatlı bir yanma hissi gibi şikâyetler bildirdi.Uzmanlar, bu etkilerin diş lekelenmesi gibi kalıcı sorunlara kıyasla “hafif” kaldığını belirtse de, kullanıcıların bu dezavantajları ne ölçüde tolere edebileceğinin hâlâ tartışmalı olduğu ifade ediliyor.Kaynak: Haber Merkezi / Journal of Herbal Medicine
Reklam